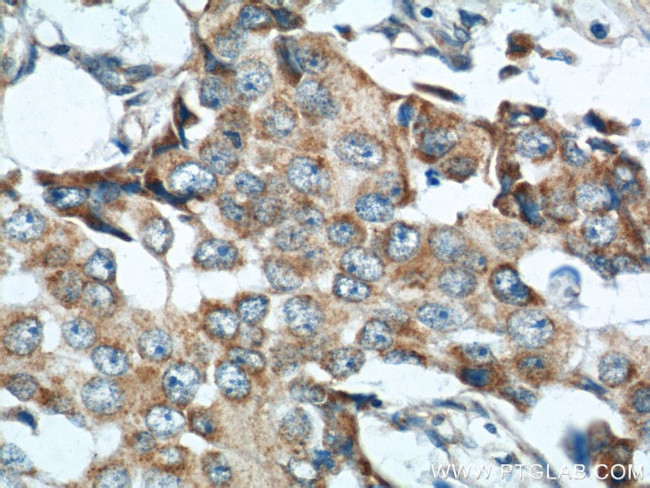
MICB Antibody in Immunohistochemistry (Paraffin) (IHC (P))
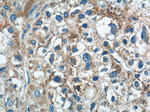
MICB Antibody in Immunohistochemistry (Paraffin) (IHC (P))

Search
Proteintech
MICB Polyclonal Antibody
{{$productOrderCtrl.translations['antibody.pdp.commerceCard.promotion.promotions']}}
{{$productOrderCtrl.translations['antibody.pdp.commerceCard.promotion.viewpromo']}}
{{$productOrderCtrl.translations['antibody.pdp.commerceCard.promotion.promocode']}}: {{promo.promoCode}} {{promo.promoTitle}} {{promo.promoDescription}}. {{$productOrderCtrl.translations['antibody.pdp.commerceCard.promotion.learnmore']}}
产品信息
14325-1-AP
种属反应
宿主/亚型
分类
类型
抗原
偶联物
形式
浓度
规格
纯化类型
保存液
内含物
保存条件
运输条件
产品详细信息
Immunogen sequence: RYNLMVLSQ DGSVQSGFLA EGHLDGQPFL RYDRQKRRAK PQGQWAEDVL GAETWDTETE DLTENGQDLR RTLTHIKDQK GVPQSSRAQT LAMNVTNFWK EDAMKTKTHY RAMQADCLQK LQRYLKSGVA IRRTVPPMVN VTCSEVSEGN ITVTCRASSF YPRNITLTWR QDGVSLSHNT QQWGDVLPDG NGTYQTWVAT RIRQGEEQRF TCYMEHSGNH GTHPVPSGKA LVLQSQRTDF PY (29-269 aa encoded by BC044218)
靶标信息
MICB encodes the highly polymorphic MHC (HLA) class I chain-related gene B. The protein product is expressed on the cell surface. It is thought that MICB functions as a stress-induced antigen that is broadly recognized by intestinal epithelial gamma delta T cells. MICB is broadly recognized by NK cells and T cells with NKG2D receptor on their surface. The complex NKG2D-MICB results in MICB expressing cytolytic T cells and NK cells against epithelial tumor cells.
仅用于科研。不用于诊断过程。未经明确授权不得转售。
篇参考文献 (0)
生物信息学
蛋白别名: ligand to the NKG2D receptor; MHC class I antigen-related protein B; MHC class I chain-related protein B; MHC class I mic-B antigen; MHC class I polypeptide-related sequence B; MHC class I-like molecule PERB11.2-IMX; MIC-B; sMICB; soluble MICB; stress inducible class I homolog; unnamed protein product
基因别名: MICB; PERB11.2
UniProt ID: (Human) Q29980
Entrez Gene ID: (Human) 4277